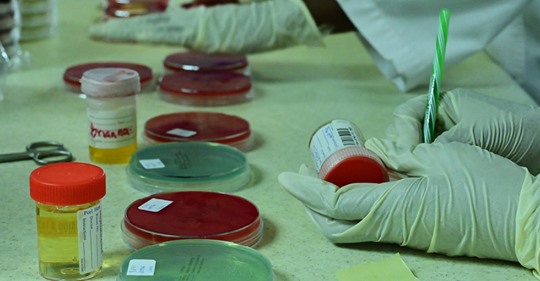
WADA & Aaaarne

Horowitz Rapport
2019-12-10
Ja då var det väl som så. 17 Significant inaccuracies and omissions’ found Horowitz listed more than 17 significant inaccuracies and omissions with the FBI’s Crossfire Hurricane probe into Trump’s campaign. The malfeasance appeared to occur during the FBI’s application for a Foreign Intelligence Sur